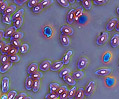
Title

The Olympus Microscopy Resource Center gallery of phase contrast photomicrography contains a large collection of images taken under a wide variety of conditions using specimens ranging from fossilized dinosaur bones to soft tissues from human and plant pathology. Use the links below to navigate to the individual entries in this colorful gallery.
 Agatized Bone
Agatized Bone Allosaurus
Allosaurus Amphibian Blood Cells
Amphibian Blood Cells Amphioxus
Amphioxus Apple Scab
Apple Scab Bird Skin
Bird Skin Black Grape Rot
Black Grape Rot Black Knot
Black Knot Black Lung Disease
Black Lung Disease Bronchial Pneumonia
Bronchial Pneumonia Carcinoma
Carcinoma Butterfly Wing Scales
Butterfly Wing Scales Cabbage Club Root
Cabbage Club Root Camarasaurus
Camarasaurus Cedar Apple Rust
Cedar Apple Rust Hamster Ovary Cells
Hamster Ovary Cells Atherosclerosis
Atherosclerosis Cooked Meat
Cooked Meat Desmids
Desmids Diabetes Mellitus
Diabetes Mellitus Down Feathers
Down Feathers Mildew of Grape
Mildew of Grape Earthworm Clitellum
Earthworm Clitellum Worm Testes/Ovaries
Worm Testes/Ovaries Ergot
Ergot Fish Cycloid Scale
Fish Cycloid Scale Fish Gills
Fish Gills Fish Skin
Fish Skin Frog Skin
Frog Skin Hadrosaurus
Hadrosaurus House Fly Eye
House Fly Eye House Fly Mouthparts
House Fly Mouthparts House Fly Wings
House Fly Wings Human Bone Sarcoma
Human Bone Sarcoma Adenocarcinoma
Adenocarcinoma Human Scar Tissue
Human Scar Tissue Human Tattoos
Human Tattoos Human Tongue
Human Tongue Hydatid Disease
Hydatid Disease Hydra Nematocysts
Hydra Nematocysts Keloid Scars
Keloid Scars Liver Cirrhosis
Liver Cirrhosis Lymph Carcinoma
Lymph Carcinoma Mammalian Cartilage
Mammalian Cartilage Metridium
Metridium Mosasaurus Vertebrae
Mosasaurus Vertebrae Multipolar Neurons
Multipolar Neurons Obelia Hydroid
Obelia Hydroid Obelia Medusa
Obelia Medusa Paramecium
Paramecium Peach Brown Rot
Peach Brown Rot Pleurodira
Pleurodira Pollen
Pollen Potato Blight
Potato Blight Emphysema
Emphysema Radiolarians
Radiolarians Raw Meat
Raw Meat Rotifers
Rotifers Sebaceous Cysts
Sebaceous Cysts Snake Skin
Snake Skin Sponge Skeleton
Sponge Skeleton Squamous Papilloma
Squamous Papilloma Starfish Arms
Starfish Arms Starfish Testes
Starfish Testes Stomach Cancer
Stomach Cancer Tapeworm
Tapeworm Tilia
Tilia Tobacco Blue Mold
Tobacco Blue Mold Tobacco Mosaic Virus
Tobacco Mosaic Virus Tracheid Cells
Tracheid Cells Uterine Adenomyosis
Uterine Adenomyosis Wheat Rust Pustules
Wheat Rust Pustules Spermogonia
Spermogonia Pine Blister Rust
Pine Blister Rust Rust of Crucifers
Rust of Crucifers